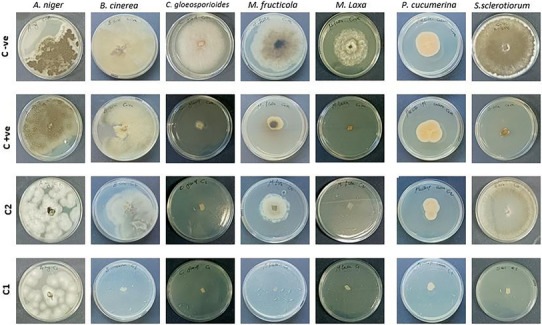
PMC12533804 – cbdv70138-fig-0003

FTIR Characterization and Bioactivity Assessment of Cinnamomum camphora Essential Oil: Antioxidant, Anti‐Enzymatic, and Antifungal Properties Against Phytopathogens
Abstract
This study explores key biopharmaceutical properties of Cinnamomum camphora essential oil (EO), including antioxidant, anti‐enzymatic, and antifungal activities, and evaluates its minimum inhibitory concentration (MIC) against some common phytopathogens. The functional groups of the EO were identified using Fourier‐transform infrared (FTIR) spectroscopy. The antioxidant capacity, evaluated using 2,2‐diphenyl‐1‐picrylhydrazyl (DPPH), ABTS, and ferric‐reducing antioxidant power (FRAP) methods, revealed a moderate activity. The antifungal activity assay showed a complete growth inhibition of Monilinia laxa, Monilinia fructicola, Sclerotinia sclerotiorum, Colletotrichum gloeosporioides, and Botrytis cinerea at a concentration of 10 000 ppm of the tested EO. However, the lowest antifungal activity (17.8%) was observed against Aspergillus niger only at the highest tested concentration. The measured MIC was 7000 ppm for M. laxa and 8000 ppm for C. gloeosporioides. The anti‐enzymatic activities of the studied EO demonstrated a low inhibitory effect on cholinesterases (AChE and BChE), but the EO exhibited inhibitory concentration (IC50) values at 7.8 ± 0.6 and 2.78 ± 0.7 mg/mL for α‐amylase and α‐glucosidase, indicating a promising antidiabetic effect. This research revealed that the studied EO possesses various biological properties, indicating its potential applicability in several agro‐pharmaceutical fields.
Article type: Research Article
Keywords: antioxidant activity, anti‐enzymatic activities, antifungal activities, essential oil, FTIR analysis
Affiliations: Laboratory of Physical Chemistry and Biology of Materials Higher Normal School of Technological Education of Skikda Skikda Algeria; Department of Pharmacy University of Salerno Fisciano Italy; Department of Agricultural, Forestry, Food and Environmental Sciences University of Basilicata Potenza Italy; Mines Metallurgy Materials Laboratory L3M National Higher School of Technology and Engineering‐ENSTI Annaba Annaba Algeria
License: © 2025 The Author(s). Chemistry & Biodiversity published by Wiley‐VHCA AG. CC BY 4.0 This is an open access article under the terms of the http://creativecommons.org/licenses/by/4.0/ License, which permits use, distribution and reproduction in any medium, provided the original work is properly cited.
Article links: DOI: 10.1002/cbdv.202500720 | PubMed: 40522779 | PMC: PMC12533804
Relevance: Moderate: mentioned 3+ times in text
Full text: PDF (1.0 MB)
Introduction
Essential oils (EOs), complex mixtures of volatile secondary metabolites, play a vital role in plant defense mechanisms, ecological interactions, and aromatic properties [ref. 1, ref. 2]. Their chemical diversity, derived from plant organs such as leaves, bark, and flowers, is heavily influenced by extraction methods, which, in turn, dictate their biological efficacy. The choice of an extraction method represents a crucial step because it directly influences the chemical composition of EOs and therefore their biological activities [ref. 3]. Recent studies highlight EOs as promising therapeutic agents, demonstrating broad‐spectrum pharmacological activities [ref. 4, ref. 5, ref. 6].
Cinnamomum camphora (L.) J. Presl, commonly known as the camphor tree, is a member of the Lauraceae family, renowned for its industrial and medicinal applications, and has been widely cultivated as ornamental trees and as a source of camphor and camphor oil [ref. 7, ref. 8, ref. 9]. Traditionally used in Asian herbal medicine to treat inflammation and rheumatism, its EOs exhibit potential in pharmaceuticals, agriculture, and cosmetics. Various parts of the camphor tree have been used to prepare EOs, which can be used in different fields, such as industry, cosmetics, pesticides, and pharmaceuticals [ref. 10]. However, the full scope of its bioactivity—particularly against phytopathogens—remains underexplored.
Camphor EO plays a vital role in combating plant pathogens due to its strong antimicrobial and antifungal properties. It contains bioactive compounds such as camphor, cineole, and borneol, which exhibit broad‐spectrum efficacy against a variety of phytopathogenic microorganisms [ref. 11]. Camphor EO has shown promising efficacy in controlling soil‐borne diseases and fungal infections in crops, serving as a natural and friendly alternative to synthetic pesticides. Supporting this, Sobhy et al. [ref. 12] investigated the antifungal activity of C. camphora methanolic extract against several common phytopathogenic fungi. Their findings demonstrated significant inhibition of mycelial growth in Fusarium oxysporum, Alternaria alternata, and Fusarium solani, with suppression rates of 60%, 49%, and 24%, respectively [ref. 12].
Many pathogens, such as bacteria, nematodes, and fungi, can cause plant diseases. Fungal infections of plants are generally the most destructive diseases in agricultural fields [ref. 13, ref. 14]. Phytopathogenic fungi pose severe threats to global agriculture, exacerbated by the overuse of synthetic fungicides. While effective, these chemicals contribute to environmental persistence, fungal resistance, and human health risks. Chemical fungicides are widely used in agriculture to protect plants from fungal infections through various mechanisms, including the destruction and inhibition of fungal cells and spores. Moreover, the low cost and simple use of this type of product lead to their overuse [ref. 15]. While effective, these chemicals contribute to environmental persistence, fungal resistance, and human health risks due to their low biodegradability and accumulation in the environment [ref. 16, ref. 17].
On the other hand, these chemical substances can contaminate soil, water, and air, leading to long‐term ecological damage. Non‐target organisms, including beneficial insects, birds, and aquatic life, may suffer from pesticide exposure, disrupting ecosystems and biodiversity. In humans, prolonged or high‐level exposure to certain pesticides has been linked to respiratory problems, skin disorders, hormonal imbalances, neurological issues, and even cancer. The widespread of chemical pesticides also contributes to the development of resistant pest strains, necessitating the use of even more toxic substances, thereby perpetuating a harmful cycle. This makes the search for new natural alternatives, such as plant‐derived EOs that offer a sustainable alternative due to their biodegradability, low toxicity, and multifunctional properties, including antifungal and antioxidant capacities [ref. 18, ref. 19, ref. 20] with low toxicity and low environmental impact [ref. 21].
Beyond agriculture, EOs are considered safe for both humans and the environment [ref. 22] and show therapeutic promise in managing non‐communicable diseases (NCDs) such as neurodegenerative disorders and diabetes [ref. 23]. For instance, acetylcholinesterase (AChE) inhibitors from EOs may alleviate Alzheimer’s symptoms [ref. 24, ref. 25, ref. 26]. However, α‐amylase/α‐glucosidase inhibitors could mitigate diabetes by modulating postprandial hyperglycemia [ref. 21]. Natural inhibitors of these two key enzymes could be developed from plants or EOs for the treatment of diabetes by reducing postprandial hyperglycemia [ref. 23, ref. 27]. For all these advantages, plant EOs have been used effectively in pharmaceuticals, food preservatives, cosmetics, and perfumes and could replace or strengthen usual synthetic products [ref. 28, ref. 29].
This study investigates the antioxidant, antifungal, and anti‐enzymatic activities of C. camphora EO, emphasizing its potential as a biopharmaceutical agent and eco‐compatible fungicide. By elucidating its biochemical properties, we aim to contribute to the development of sustainable solutions for agriculture and medicine. In particular, Fourier‐transform infrared (FTIR) spectroscopy was employed to analyze the studied EO and confirm the presence of key functional groups. The antiradical activity of camphor EO was assessed using three standard assays: 2,2‐diphenyl‐1‐picrylhydrazyl (DPPH), ABTS•⁺ radical scavenging, and ferric‐reducing antioxidant power (FRAP). In addition, the anti‐enzymatic potential was determined by evaluating AChE, α‐amylase, and α‐glucosidase inhibition activities. The antifungal efficacy of camphor EO was tested against seven phytopathogenic fungi: Monilinia laxa, Monilinia fructicola, Sclerotinia sclerotiorum, Colletotrichum gloeosporioides, Aspergillus niger, Botrytis cinerea, and Plectosphaerella cucumerina.
Results and Discussion
Yield and Chemical Composition
The EO yield obtained from C. camphora provided a rate of approximately 0.95%. A slight decrease in the yield value was observed compared to our previous study conducted by Cheribot Cherif et al. [ref. 30], which may be due to the time of harvest between May 2023 and March 2024 [ref. 31]. According to our previous study [ref. 30], the gas chromatography–mass spectrometry (GC–MS) analysis allowed the identification of 69 components, which represented 99.57% of the total EO components. The major compounds were camphor (36.81%), α‐pinene (9.91%), d‐limonene (8.63%), and camphene (6.99%), accompanied by other constituents at relatively low levels: β‑myrcene (4.80%), eucalyptol (4.58%), and β‐pinene (3.68%). The identified EO compounds are classified into four main classes: monoterpene hydrocarbons (41.11%), oxygenated monoterpenes (49.22%), sesquiterpene hydrocarbons (9%), and oxygenated sesquiterpene (0.07%) [ref. 30].
FTIR Analysis
FTIR spectroscopy was used to identify the functional groups in the studied EO. The results obtained in this study (Figure 1) are in accordance with those previously published by [ref. 32, ref. 33], in which the peaks located at around 2956.52, 2877.68, 1741.45, 1448.70, 1376.81, and 748.41 cm−1 are attributed to camphor. The spectral bands at 2956.52 and 2877.68 cm−1 are due to the asymmetric and symmetric (C–H) stretching in alkanes, respectively [ref. 34]. These two bands cause a signal at 1448.70 cm−1 [ref. 35] that is assigned to CH3/CH2 bendings [ref. 36]. The strong band at 1741.45 cm−1 corresponds to the stretching vibration characteristic for the keto groups substituted on a cyclopentane ring system present in camphor [ref. 37]. The band at 1376.81 cm−1 is due to the deformation vibration of dimethyl‐substituted methylene groups contained in camphor [ref. 37]. The peaks at 1323.48 and 1280.56 cm−1 could be attributed to the O–H group bending [ref. 35]. The band at 1087.54 cm−1 is attributed to symmetric stretches of group C–O–C [ref. 38]. The spectral band at 1037.68 cm−1 corresponds to the C–O deforming in secondary alcohols and aliphatic ethers [ref. 39]. The peak at 855.65 cm−1 may be linked to the vinylidene C−H out‐of‐plane bend present in camphene [ref. 40]. The peak at 748.41 cm−1 is assigned to benzene rings CH vibration absorption [ref. 41, ref. 42], and the weak band at 648.12 cm−1 may correspond to the ring deformation of α‐pinene [ref. 36].

Antioxidant Activity
The results obtained showed that our tested EO has a moderate antioxidant activity (Table 1). In DPPH assay, the results showed that the C. camphora EO has a low antioxidant power with an IC50 value equal to 162.5 µg/mL. This value shows that the studied EO is less effective compared to the standard used (ascorbic acid), whose IC50 was 24.3 µg/mL, in agreement with Ioannou et al. [ref. 43], who reported that the lower IC50 value may indicate the higher antioxidant activity. These obtained results are consistent with those of Kanyal et al. [ref. 44], where the measured IC50 of the EO from shade‐dried C. camphora leaves cultivated in India resulted in 25 ± 0.03 µg/mL. On the other hand, this activity is stronger than that found by Ling et al. [ref. 31], who studied the antioxidant activity of the EO extracted from the leaves of seven varieties of C. camphora and found that the IC50 values ranged between 6.88 ± 0.15 and 28.13 ± 0.44 mg/mL.
TABLE 1: Antioxidant activity of Cinnamomum camphora essential oil (EO).
| C. camphora EO | Ascorbic acid | Trolox | |
|---|---|---|---|
| DPPH (IC50 µg/mL) | 162.5 | 24.3 | — |
| ABTS (IC50 µg/mL) | 589.9 | — | 5.8 |
| FRAP (mmol Fe(II)/g) | 12.5 | — | 5.6 |
Abbreviations: :DPPH, 2,2‐diphenyl‐1‐picrylhydrazyl; FRAP, ferric‐reducing antioxidant power.
In the ABTS assay, the studied EO exhibited low activity, with an IC50 of 589.9 µg/mL compared to the standard Trolox, which had an IC50 of 5.8 µg/mL. Nevertheless, the C. camphora EO demonstrated a higher free radical scavenging ability than those reported by Ling et al. [ref. 31], who found IC50 values ranging from 19.08 ± 0.02 to 117.22 ± 5.4 mg/mL across seven varieties of C. camphora EO. Regarding the FRAP assay, C. camphora EO exhibited a value of 12.5 mmol Fe(II)/g, surpassing that of Trolox (5.6 mmol Fe(II)/g). This result aligns with findings by Zakaria et al. [ref. 45], who reported that the FRAP value of C. glanduliferum leaf EO (63.1 mmol Fe(II)/g) was higher than that observed in ascorbic acid (48.33 mmol Fe(II)/g).
The antioxidant effect of EO is probably related to its chemical profile, especially its monoterpenes. According to a study carried out by Tian et al. [ref. 8], the seasonal variation has an effect on monoterpene synthesis in C. camphora. The results obtained for the camphor chemotype showed that high temperatures cause an increase in the number of monoterpenes produced and that in summer new monoterpenes appear compared to other seasons (spring and autumn), which makes the choice of the season of use of this plant a crucial step.
Anti‐Enzymatic Activities
The anti‐enzymatic activities were reported in Table 2. Cholinesterase inhibitory activity was evaluated by the ability of the EO to inhibit AChE and BChE activities, whereas antidiabetic activity was evaluated by the ability to inhibit α‐amylase and α‐glucosidase. C. camphora EO was more active against α‐glucosidase with an IC50 value of 2780 µg/mL compared to other enzymes that showed IC50 values ranging from 7800 to 20 200 µg/mL compared to galantamine and acarbose used as positive controls.
TABLE 2: Inhibitory effects of the Cinnamomum camphora essential oil (EO) on acetylcholinesterase (AChE), BChE, α–amylase, and α‐glucosidase.
| Enzymes | C. camphora EO (IC50 µg/mL) | Galantamine (IC50 µg/mL) | Acarbose (IC50 µg/mL) |
|---|---|---|---|
| AChE | 10 500 ± 400 | 1.2 ± 0.4 | — |
| BChE | 20 200 ± 800 | 4.7 ± 1.4 | — |
| α‐Amylase | 7800 ± 600 | — | 10.0 ± 5.2 |
| α‐Glucosidase | 2780 ± 700 | — | 960.0 ± 0.47 |
Note: Data are the means ± standard deviation of three experiments.
There are few studies on the anti‐enzymatic activity of C. camphora EO. In particular, our results corroborate with study of Bai et al. [ref. 46] that showed no significant effect of C. camphora EO on the activity of AChE but disagree with Jugreet et al. [ref. 47] that reported no inhibition on α‐glucosidase. Instead, Rawat et al. [ref. 48] reported that C. camphora EO presented a high AChE inhibitory potential (53.61% ± 2.66%) compared with C. tamala (46.12% ± 1.52%) at the concentration of 1000 µg/mL; the C. camphora EO was characterized by the abundance of oxygenated monoterpenes (70.63%).
Available literature reported data also on other species of Cinnamomum genus. Kiran et al. [ref. 49] studied the potential of C. zeylanicum EO that inhibited the activity of both cholinesterases in a dose‐dependent manner. This species also showed a highly effective inhibition against α‐amylase [ref. 50] and α‐glucosidase [ref. 51]. Likewise, Cinnamomum chemungianum and Cinnamomum wightii EOs exhibited a good α‐amylase and α‐glucosidase inhibitory activity [ref. 52, ref. 53].
Previous studies have described the ability of some compounds present in EOs, such as 1,8‐cineole, α‐pinene, β‐pinene, camphor, γ‐terpinene, eugenol, and carvacrol, to inhibit cholinesterases [ref. 54, ref. 55, ref. 56]. Farag et al. [ref. 57] also found that some compounds are more effective than others, such as 1,8‐cineole, which showed better inhibition of AChE than crude camphor EO.
Antifungal Activity
The antifungal study indicates that C. camphora EO showed significant antifungal activity against phytopathogenic fungi in a dose‐dependent manner (Figures 2 and 3). This EO showed greater efficacy than the standard used (azoxystrobin/cycloheximide) against all strains tested except for A. niger. Several studies have shown that a specific fungus can react differently to one EO compared to another, which makes fungi sensitive to some EOs and resistant to others [ref. 58, ref. 59, ref. 60]. The sample caused 100% inhibition of mycelial growth of M. laxa, M. fructicola, S. sclerotiorum, C. gloeosporioides, and B. cinerea at the tested concentration 10 000 ppm, whereas 80% of P. cucumerina at the same concentration. On the other hand, A. niger showed lower sensitivity to the tested EO (17.8%), with inhibition of the production of spores at the higher tested concentration 10 000 ppm. At the concentration of 7000 ppm, M. laxa, M. fructicola, C. gloeosporioides, and P. cucumerina were inhibited at more than 50%, in contrast to S. sclerotiorum, A. niger, and B. cinerea, which were inhibited at 4.2%, 5.4%, and 29.4%, respectively (Table 3).

TABLE 3: Antifungal activity of Cinnamomum camphora essential oil (EO).
| Mycelium inhibition (%) | |||
|---|---|---|---|
| 10 000 ppm | 7000 ppm | C+ve | |
| Monilinia laxa | 100 | 90.1 | 100 |
| Monilinia fructicola | 100 | 56.5 | 72.35 |
| Sclerotinia sclerotiorum | 100 | 4.2 | 92.81 |
| Colletotrichum gloeosporioides | 100 | 76.1 | 76.72 |
| Aspergillus niger | 17.8 | 5.4 | 3.57 |
| Plectosphaerella cucumerina | 80.0 | 51.3 | 26.95 |
| Botrytis cinerea | 100 | 29.4 | 13.5 |
Note: Where C+ve is a mixture of azoxystrobin and cycloheximide.
Several studies have reported the antifungal potential of C. camphora EO, supporting its use as a preservative for fruits and vegetables, a powerful alternative to chemical fungicides [ref. 61, ref. 62]. To our knowledge, this is the first study of antifungal activity of C. camphora leaves EO against M. laxa, M. fructicola, S. sclerotiorum, and P. cucumerina. The antifungal activity of C. camphora EO showed significant antifungal activity against phytopathogenic fungi in comparison to positive control. According to the results obtained by Marei et al. [ref. 63], limonene and eucalyptol showed promising antifungal activity against A. niger and other plant pathogenic fungi. Camphor EO was the most effective EO against A. niger, and that camphor oil inhibited 97.4% of the live spores for A. niger [ref. 64]. Other studies reported that C. camphora EO has antimicrobial activity against A. alternata, Curvularia lunata, Candida sp., Bacillus cereus, and Staphylococus aureus [ref. 65, ref. 66, ref. 67]. Pitarokili et al. [ref. 68] tested the antifungal activity of Salvia fruticosa EO against some phytopathogenic fungi, and they found that the inhibition of S. sclerotiorum mycelium growth was accompanied by a decrease in sclerotia production. They attributed this activity to the synergy between the two dominant terpenes in the EO (1,8‐cineole and camphor).
The antifungal activity may be due to synergy between EO components, because camphor, limonene, α‐pinene, β‐pinene, and 1,8‐cineole had greater antifungal activity when used together than when each constituent was used alone [ref. 65, ref. 69, ref. 70]. EOs are rich in terpenes, which are characterized by their powerful antimicrobial activity [ref. 71]. This activity can be attributed to their lipophilic nature and low molecular weight, which enable them to disrupt the cell membrane, cause cell death, or inhibit the sporulation and germination of fungi [ref. 72].
Minimum Inhibitory Concentration (MIC) of Antifungal Activity
The MICs of C. camphora EO against M. laxa and C. gloeosporioides were 7000 and 8000 ppm, respectively (Table 4 and Figure 4). The MIC values obtained were higher than that obtained by Yan et al. [ref. 73], who tested the antifungal activity of C. camphora EO against Trichoderma viride, A. niger, and Penicillium citrinum, and the MIC was 500 µL/L for all three fungi, which indicates higher activity than that obtained by our EO. On the other hand, Oliveira Filho et al. [ref. 21] obtained lower antifungal activity of C. camphora EO compared to other EOs tested with 750 < MIC ≤ 1000 µL/L against Rhizopus stolonifer, but this value is still better than the MIC value obtained in our study.
TABLE 4: Minimum inhibitory concentrations (MIC) of studied Cinnamomum camphora essential oil (EO) against Monilinia laxa and Colletotrichum gloeosporioides.
| Absorbance at 450 nm | ||||||||
|---|---|---|---|---|---|---|---|---|
| C1 | C2 | C3 | C4 | C5 | C6 | C−ve | MIC ppm | |
| M. laxa | 0.130 | 0.146 | 0.150 | 0.164 | 0.402 | 0.692 | 0.975 | 7000 |
| C. gloeosporioides | 0.402 | 0.453 | 0.507 | 0.812 | 0.862 | 0.987 | 1.200 | 8000 |
Note: Where C1: 10 000, C2: 9000, C3: 8000, C4: 7000, C5: 6000, C6: 5000 (ppm), and C−ve: negative control plates containing only PDB.

Conclusion
The current study comprehensively demonstrates the promising bioactivity of C. camphora EO, supported by its complex chemical composition rich in oxygenated monoterpenes such as camphor, α‐pinene, and 1,8‐cineole. FTIR analysis confirmed the presence of key functional groups characteristic of these compounds. The EO exhibited moderate antioxidant potential, with appreciable ferric‐reducing capacity, highlighting its potential application as a natural antioxidant in the food and pharmaceutical industries. Although its inhibitory effects on AChE, α‐amylase, and α‐glucosidase were relatively modest compared to standard drugs, the EO still provides a promising foundation for developing natural enzyme inhibitors with reduced side effects. Most notably, the EO demonstrated potent antifungal activity against a range of economically significant phytopathogenic fungi, achieving complete inhibition of several species at high concentrations. These findings underscore its strong potential as an eco‐friendly alternative to synthetic fungicides, aligning with global efforts to reduce chemical pesticide usage and environmental contamination. The synergistic effects among the EO’s terpenoid constituents likely contribute to its broad‐spectrum antimicrobial efficacy. Overall, C. camphora EO emerges as a valuable candidate for integrated pest management, as well as a bioactive agent in pharmaceutical and nutraceutical formulations. Future studies should focus on optimizing extraction methods, evaluating the EO’s in vivo efficacy, and elucidating the molecular mechanisms underlying its bioactivities to pave the way for practical applications in sustainable agriculture and health care.
Experimental Section
Isolation and Chemical Investigation
The studied EO has been extracted from leaves of C. camphora plant located at the Botanical Extension Center, University of August 20, 1955, Skikda, North‐east Algeria. Sampling was carried out in March 2024, and the plant was identified by Dr. Sakhraoui Nora, Department of Ecology and Environment, University of August 20, 1955, Skikda. The voucher specimen of the plant (PPL 01/2023) was deposited in the herbarium of Plant Physiology Laboratory, Higher Normal School of Technological Education of Skikda, Algeria. The leaves were carefully separated from their peduncles and cleaned and left to dry for 15 days in darkness. After that, 100 g of the leaves was subjected to hydrodistillation for 3 h using a Clevenger apparatus. The obtained EO was stored in a refrigerator at 4°C until used. The chemical analysis of volatile oils was carried out by GC–MS, as described by [ref. 30].
Fourier‐Transform Infrared Spectroscopy
The FTIR analysis was applied to the studied EO sample to confirm the presence of functional groups. The experiment was performed by using a SHIMADZU FTIR‐8000 spectrometer (Tokyo, Japan) apparatus equipped with a single‐reflection ATR accessory and IR Pilot software.
A small drop of the EO was placed on the ATR crystal, and the spectrum was acquired in the range of frequency of 4000–600 cm−1, with a wavenumber resolution of 4 cm−1. The measurement was performed in duplicate, and the recorded IR spectrum represents the average of 20 scans.
Antioxidant Activity
DPPH Assay
Antiradical activity of the studied EO was evaluated using DPPH assay following the methodological procedures of the basic principles of Brand‐Williams et al. [ref. 74]. This method was used for determining the antiradical activity of a compound based on the use of the stable free radical DPPH. The mechanism is based on the ability of tested compounds to reduce the DPPH radical (deep violet) into a neutral stable molecule (pale yellow). A stock radical solution of DPPH was prepared by dissolving 20 mg of DPPH in 15 mL ethanol.
This method was used for determining the antiradical activity of EO dissolved in DMSO at 125, 250, 500, and 1000 µg/mL. Fifty µL of each concentration was mixed with DPPH (1:20, v/v) and incubated in darkness for 30 min at room temperature (25°C). All samples were centrifuged at 7155 × g for 5 min, and the absorbance was measured at 515 nm on a UV/VIS spectrophotometer (LKB Biochrom 4050 Ultrospec II, Cambridge, England), whereas ethanol was used as a reference sample. Ascorbic acid was used as a reference standard. The solutions were prepared fresh for the analysis, and all determinations were carried out in triplicate and the evaluation of DPPH % using the following equation:
where Abs. C is the absorbance of control with no radical scavenger, and Abs. S is the absorbance of remaining DPPH in the presence of a scavenger.
ABTS•+ Free Radical Scavenging Activity
The ABTS•+ radical assay was carried out according to the protocol reported by Ud‐Daula et al. [ref. 75] with minor modifications. The mixture of ABTS (7 mM) and potassium persulfate (2.45 mM) solutions was incubated in the dark at 25°C for 16 h to generate the ABTS radical (ABTS⁺) prior to use. The ABTS+ solution was diluted with distilled water to an OD of 0.800 at 734 nm. Ten µL of different concentrations dissolved in methanol (0.1–1 mg/mL) and 190 µL of ABTS were placed in the wells for analysis. Ten µL of sodium phosphate buffer and 190 µL of distilled water were added to the wells for the control. The results were expressed as IC50 values, which are the amount of EOs necessary to reduce the radical ABTS activity by 50%. Trolox (6‐hydroxy‐2,5,7,8‐tetramethylchroman‐2‐carboxylic acid) was used as the drug reference.
FRAP Assay
The FRAP assay was carried out according to the method described in the literature [ref. 76]. Briefly, a solution consisting of a 10:1:1 ratio of 23 mM acetate buffer (pH 3.6), 10 mM of tripyridyl triazine (TPTZ) in HCl (40 mM), and FeCl3 (20 mM), respectively, was prepared as the FRAP reagent. The assay was performed in 96‐well microplate. In each well, 264 µL of FRAP reagent and 8 µL of EO dissolved in methanol at different concentrations (0.1–1 mg/mL) were placed. The reaction mixture was incubated at 37°C for 30 min in dark conditions. Absorbance was read at 593 nm using a Thermo Scientific Multiskan GO spectrophotometer (Thermo Fischer Scientific, Vantaa, Finland). The absorbance of the blank (FRAP reagent) was subtracted from all absorbances of the sample to determine the FRAP value for each sample. Trolox was used as the drug reference.
Anti‐Enzymatic Activity
Cholinesterases Inhibition
The AChE inhibitory activity for the studied EO was carried out using Ellman’s colorimetric method [ref. 77] with some modifications. Ten µL of different concentrations of EOs dissolved in methanol (50, 25, 12.5, 6.25 mg/mL) were previously prepared, then 415 µL of a solution of Tris–HCl (0.1 M, pH 8) and 25 µL of ACHE were added to each concentration, and the mixture was placed in the incubator (15 min, 37°C). Seventy‐five uL of acetylthiocholine iodide (AChI) and 475 µL of 5,5‐dithio‐bis‐2‐nitrobenzoic acid (DTNB) were added. The reactants were mixed in a 96‐well microplate. The mixture was pre‐incubated at 37°C for 30 min. Absorbance was read at 412 nm in a spectrophotometer (Thermo Fischer Scientific, Vantaa, Finland). Galantamine was the reference drug. The inhibition of the enzymatic activity of the enzymes studied was calculated as a percentage using the following formula:
where AC represents negative control absorbance; and AE represents enzyme solution absorbance after contact with EOs. The IC50, which represents the EO concentration that causes 50% inhibition, was derived by plotting the percentage inhibition versus sample concentrations. The experiments were carried out in triplicate.
α‐Amylase Inhibition Assay
In this study, the assessment of amylase activity was carried out according to the method of Bernfeld [ref. 78], with some modifications. One hundred µL of different concentrations of EO solubilized in methanol (10, 5, 2.5, 1.25 mg/mL), along with 200 µL of phosphate buffer (20 mM with pH = 6.9) and 100 µL of aqueous alpha‐amylase solution (1 U/mL), were mixed and then placed in a tube for 10 min at 37°C. Then, 180 µL of a starch solution (1% w/v) was added, and the reaction continued after incubation (at 37°C for 10 min). A volume of 180 µL of dinitrosalicylic acid reagent (ADNS) was added, and the mixture was incubated (at 100°C for 10 min). The absorbance was read at 540 nm with a Thermo Scientific Multiskan GO (Thermo Fischer Scientific, Vantaa, Finland). The experiments were carried out in triplicate. The inhibition of the enzymatic activity of α‐amylase was calculated as a percentage using the same formula used for cholinesterases.
α‐Glucosidase Inhibition Assay
In this test, 10 µL of different concentrations of EO solubilized in methanol (10, 5, 2.5, 1.25 mg/mL) and 150 µL of phosphate buffer (0.1 M, pH 7.0), together with 15 µL of 1 U/mL α‐glucosidase enzyme solution, were placed in a 96‐well plate. The plate was incubated at 37°C for 5 min. Then, 75 µL of 2.0 mM 4‐nitrophenyl‐d‐glucopyranoside (pNPG) was added, and the plate was incubated again for 10 min at 37°C. The absorbance was read at 405 nm using a Thermo Scientific Multiskan GO spectrophotometer (Thermo Fischer Scientific, Vantaa, Finland). Acarbose was used as a positive control. The experiments were carried out in triplicate. The inhibition of the enzymatic activity of α‐glucosidase was calculated as a percentage using the same formula used for cholinesterases and α‐amylase [ref. 79].
Antifungal Activity
The tested microscopic fungi were obtained from the fungal collection of the Department of Agricultural, Forestry, Food and Environmental Sciences (DAFE), University of Basilicata, Potenza (Italy), and were sub‐cultured on PDA nutrient media for 96 h at 24°C. The tested fungi were previously identified by morphological and molecular methods. The antifungal activity of the studied C. camphora EO was tested against seven phytopathogenic fungi: M. laxa (Aderh. & Ruhland) Honey, M. fructicola (G. Winter) Honey, S. sclerotiorum (Lib.) de Bary, C. gloeosporioides (Penz.) Penz. & Sacc., A. niger Tiegh, B. cinerea Pers, and P. cucumerina (Lindf.) W. Gams. The studied EO was used at 7000 and 10 000 ppm incorporated into PDA as reported by Gruľová et al. [ref. 80]. Plates containing only PDA were considered the negative control, whereas the positive control was a mixture of azoxystrobin/cycloheximide (1:1; v/v) used at a final concentration of 0.8 µg/mL. All plates were left overnight until complete dryness, and then a 0.5 mm of agar disk of each tested fungus was inoculated in the center of the plates and incubated at 22°C ± 2°C for 96 h. The antifungal activity was determined by measuring the diameter of the fungal mycelium (mm), and the percentage of mycelium growth inhibition (MGI %) was calculated using the following equation:
where MGI % is the mycelium growth inhibition percentage; DM is the diameter of mycelium (mm).
Determination of the Antifungal MIC (96‐Well Microplate Method)
The antifungal MIC of C. camphora EO was evaluated against M. laxa and C. gloeosporioides on a 96‐well microplate [ref. 81]. Briefly, different concentrations of EO at 10 000, 9000, 8000, 7000, 6000, and 5000 ppm were inoculated with each single fungal suspension and Potato Dextrose Broth (PDB), then incubated for 48 h at 22°C. The absorbance was read using a microplate reader instrument (DAS s.r.l., Rome, Italy) at 450 nm.
Statistical Analysis
The obtained results were statistically analyzed, applying one‐way ANOVA using the Statistical Package for the Social Sciences (SPSS) version 13.0 (Prentice Hall: Chicago, IL, USA, 2004). The Tukey B post hoc multiple comparison test was used to evaluate the significance level with a probability of p < 0.05.
Author Contributions
Maroua Cheribot Cherif: formal analysis, investigation, writing original draft. Hicham Boughendjioua: conceptualization, supervision, validation. Lucia Caputo: formal analysis, data curation, investigation. Ippolito Camele: conceptualization, supervision, validation, investigation, writing – review and editing. Tarek Tahraoui: conceptualization, investigation, visualization. Vincenzo De Feo: investigation, supervision, validation, writing – review and editing. Hazem S. Elshafie: conceptualization, formal analysis, data curation, validation, writing – review and editing.
Disclosure
This manuscript reflects only the authors’ views and opinions; neither the European Union nor the European Commission can be considered responsible for them.
Consent
The authors have nothing to report.
Conflicts of Interest
The authors declare no conflicts of interest.
References
- Essential Oils Pharmacological Activity: Chemical Markers, Biogenesis, Plant Sources, and Commercial Products,”. Process Biochemistry, 2024
- Properties and Applications of Essential Oils: A Review,”. Journal of Ecological Engineering, 2024
- An Overview of the Biological Effects of Some Mediterranean Essential Oils on Human Health,”. BioMed Research International, 2017. [PubMed]
- Biochemical Characterization, Antifungal Activity, and Relative Gene Expression of Two Mentha Essential Oils Controlling Fusarium oxysporum, the Causal Agent of Lycopersicon esculentum Root Rot,”. Plants, 2022. [PubMed]
- Evaluation of the Antimicrobial Activity of Four Plant Essential Oils Against Some Food and Phytopathogens Isolated From Processed Meat Products in Egypt,”. Foods, 2022. [PubMed]
- Essential Oils: Chemistry and Pharmacological Activities,”. Biomolecules, 2023. [PubMed]
- The Chemical Composition of Essential Oils From Cinnamomum camphora and Their Insecticidal Activity Against the Stored Product Pests,”. International Journal of Molecular Sciences, 2016. [PubMed]
- Seasonal Emission of Monoterpenes From Four Chemotypes of Cinnamomum camphora ,”. Industrial Crops and Products, 2021
- Chemical Variation and Environmental Influence on Essential Oil of Cinnamomum camphora ,”. Molecules (Basel, Switzerland), 2023. [PubMed]
- Phytochemistry and Applications of Cinnamomum camphora Essential Oils,”. Molecules (Basel, Switzerland), 2022. [PubMed]
- Antifungal Activity of Camphor Against Four Phytopathogens of Fusarium,”. South African Journal of Botany, 2022
- Phytochemical Characterization and Antifungal Efficacy of Camphor (Cinnamomum camphora L.) Extract Against Phytopathogenic Fungi,”. Separations, 2023
- Antioxidant and Antifungal Activity of Selected Medicinal Plant Extracts Against Phytopathogenic Fungi,”. African Journal of Traditional, Complementary, and Alternative Medicines, 2016
- Review of Essential Oils as Antifungal Agents for Plant Fungal,”. Ziraat Fakültesi Dergisi, 2019
- Recent Approaches towards Control of Fungal Diseases in Plants: An Updated Review,”. Journal of Fungi, 2021. [PubMed]
- Efficacy of Essential Oil Vapours in Reducing Postharvest Rots and Effect on the Fruit Mycobiome of Nectarines,”. Journal of Fungi, 2024. [PubMed]
- Phytochemicals as Alternative Fungicides for Controlling Plant Diseases: A Comprehensive Review of Their Efficacy, Commercial Representatives, Advantages, Challenges for Adoption, and Possible Solutions,”. Heliyon, 2023. [PubMed]
- Biological Investigations of Essential Oils Extracted From Three Juniperus Species and Evaluation of Their Antimicrobial, Antioxidant and Cytotoxic Activities,”. Journal of Applied Microbiology, 2020. [PubMed]
- Chemical Composition and Antimicrobial Properties of Mentha×Piperita Cv. ‘Kristinka’ Essential Oil,”. Plants, 2021. [PubMed]
- Blended Formulations of Oregano‐Sage Essential Oils: Antimicrobial, Phytotoxic, and Anti‐Quorum Sensing Investigations,”. Journal of Biological Research—Bollettino Della Società Italiana Di Biologia Sperimentale, 2024
- Essential Oils as Natural Fungicides to Control Rhizopus stolonifer‐Induced Spoiled of Strawberries,”. Biointerface Research in Applied Chemistry, 2021
- Natural Antioxidants From Medicinal and Aromatic Plants: A Review,”. Pharma Innovation International Journal, 2023
- Selected Essential Oils Inhibit Key Physiological Enzymes and Possess Intracellular and Extracellular Antimelanogenic Properties In Vitro,”. Journal of Food and Drug Analysis, 2018. [PubMed]
- Inhibition of Acetylcholinesterase Activity by Essential Oils of Mentha Species,”. Journal of Agricultural and Food Chemistry, 1998
- Neuroprotective and Anti‐Aging Potentials of Essential Oils From Aromatic and Medicinal Plants,”. Frontiers in Aging Neuroscience, 2017. [DOI | PubMed]
- Therapeutic Potential of Aromatic Plant Extracts in Alzheimer’s Disease: Comprehensive Review of Their Underlying Mechanisms,”. CNS Neuroscience & Therapeutics, 2023. [PubMed]
- α‐Amylase and α‐Glucosidase Antidiabetic Potential of Ten Essential Oils From Calophyllum inophyllum Linn,”. Iberoamerican Journal of Medicine, 2020
- Essential Oil Composition, Antioxidant Assay and Antifungal Activity of Essential Oil and Various Extracts of Alpinia allughas (Retz.) Roscoe Leaves,”. Cogent Chemistry, 2015. [DOI]
- Antifungal Activity of Volatile Organic Compounds From Essential Oils Against the Postharvest Pathogens Botrytis cinerea, Monilinia fructicola, Monilinia fructigena, and Monilinia laxa ,”. Frontiers in Plant Science, 2023. [PubMed]
- Chemical Composition of Essential Oil From the Leaves of Cinnamomum camphora (L.) J. Presl,”. Journal of Phytology, 2024. [DOI]
- Chemical Composition and Antioxidant Activity of the Essential Oils of Citral‐Rich Chemotype Cinnamomum camphora and Cinnamomum bodinieri ,”. Molecules (Basel, Switzerland), 2022. [PubMed]
- A Diagnostic Tool for Assessing the Conservation Condition of Cellulose Nitrate and Acetate in Heritage Collections: Quantifying the Degree of Substitution by Infrared Spectroscopy,”. Heritage Science, 2020
- Vibrational Spectroscopic Methods for the Identification and Distinction of Essential Oils in Genus Ocimum L.: A Chemometric Approach,”. Journal of King Saud University—Science, 2022
- Attenuated Total Reflectance–Fourier Transform Infrared (ATR–FTIR) Spectroscopy Coupled With Chemometric Analysis for Detection and Quantification of Adulteration in Lavender and Citronella Essential Oils,”. Phytochemical Analysis, 2021. [PubMed]
- Chemical Analysis and Anti‐Proliferative Activity of Campania Thymus vulgaris Essential Oil,”. Journal of Essential Oil Research, 2017
- Raman Spectroscopy as an Analytical Tool for Analysis of Vegetable and Essential Oils,”. Flavour and Fragrance Journal, 2014
- Attenuated Total Reflectance–Fourier Transform Infrared Spectroscopy on Intact Dried Leaves of Sage (Salvia officinalis L.): Accelerated Chemotaxonomic Discrimination and Analysis of Essential Oil Composition,”. Journal of Agricultural and Food Chemistry, 2015. [PubMed]
- Valorization of Eucalyptus Leaves by Essential Oil Extraction as an Added Value Product in Mexico,”. Waste and Biomass Valorization, 2017
- Assessment of Essential Oils From Five Santalum Species Using ATR‐Fourier Transform Mid‐Infrared Spectroscopy and GC‐MS Combined With Chemometric Analysis,”. Journal of Essential Oil Research, 2019
- Rapid Classification and Recognition Method of the Species and Chemotypes of Essential Oils by ATR‐FTIR Spectroscopy Coupled With Chemometrics,”. Molecules (Basel, Switzerland), 2022. [PubMed]
- Analysis and Evaluation of Essential Oil Components of Cinnamon Barks Using GC–MS and FTIR Spectroscopy,”. Industrial Crops and Products, 2013
- Chemical Composition and Antioxidant, Antimicrobial, and Antiproliferative Activities of Cinnamomum Zeylanicum Bark Essential Oil,”. Evidence‐ Based Complementary and Alternative Medicine, 2020
- Phenolic Profile, Antioxidant Activity, and Chemometric Classification of Carob Pulp and Products,”. Molecules (Basel, Switzerland), 2023. [DOI | PubMed]
- Aroma Profile, Antioxidant and Anti‐Inflammatory Properties of Cinnamomum camphora L. Essential Oil as Affected by Various Drying Techniques,”. Journal of Essential Oil Research, 2024
- Evaluation of Antioxidant Activity of Cinnamomum glanduliferum Leaf Oil Using Several In‐Vitro Assays,”. Archives of Pharmaceutical Sciences Ain Shams University, 2023
- The Acaricidal Activity and Enzymatic Targets of the Essential Oils of Cinnamomum Cassia and Cinnamomum camphora and Their Major Components Against Haemaphysalis longicornis (Acari: Ixodidae),”. Industrial Crops and Products, 2024
- GC/MS Profiling, In Vitro and In Silico Pharmacological Screening and Principal Component Analysis of Essential Oils From Three Exotic and Two Endemic Plants From Mauritius,”. Chemistry & Biodiversity, 2021. [PubMed]
- Comparative Chemical Composition and Acetylcholinesterase (AChE) Inhibitory Potential of Cinnamomum camphora and Cinnamomum tamala ,”. Chemistry & Biodiversity, 2023. [PubMed]
- Assessment of Preservative Potential of Cinnamomum zeylanicum Blume Essential Oil Against Food Borne Molds, Aflatoxin B1 Synthesis, Its Functional Properties and Mode of Action,”. Innovative Food Science & Emerging Technologies, 2016. [DOI]
- Comprehensive Metabolite Profiling of Cinnamon (Cinnamomum zeylanicum) Leaf Oil Using LC‐HR/MS, GC/MS, and GC‐FID: Determination of Antiglaucoma, Antioxidant, Anticholinergic, and Antidiabetic Profiles,”. Life, 2023. [PubMed]
- GC/MS Profile and In‐Vitro Antidiabetic Activity of Cinnamomum zeylanicum Blume., Bark and Trachyspermum ammi (L.) Sprague, Seeds,”. Journal of Essential Oil Bearing Plants, 2019
- Cumin Scented Leaf Essential Oil of Cinnamomum chemungianum: Compositions and Their In Vitro Antioxidant, α‐Amylase, α‐Glucosidase and Lipase Inhibitory Activities,”. Natural Product Research, 2018. [PubMed]
- Screening of Chemical Composition, in Vitro Antioxidant, α‐Amylase and α‐ Glucosidase Inhibitory Activities of the Leaf Essential Oils of Cinnamomum wightii From Different Populations,”. Natural Product Communications, 2018
- Terpenes, Phenylpropanoids, Sulfur and Other Essential Oil Constituents as Inhibitors of Cholinesterases,”. Current Medicinal Chemistry, 2020. [PubMed]
- Potential Acetylcholinesterase, Lipase, α‐Glucosidase, and α‐Amylase Inhibitory Activity, as Well as Antimicrobial Activities, of Essential Oil From Lettuce Leaf Basil (Ocimum basilicum L.) Elicited With Jasmonic Acid,”. Applied Sciences, 2020
- Potential of Essential Oil‐Based Anticholinesterase Insecticides Against Anopheles Vectors: A Review,”. Molecules (Basel, Switzerland), 2022. [PubMed]
- Anti‐Acetylcholinesterase Activity of Essential Oils and Their Major Constituents From Four Ocimum Species,”. Zeitschrift Fur Naturforschung. C, Journal of Biosciences, 2016. [PubMed]
- The Effect of Essential Oils on the Development of Phytopathogenic Fungi,”. Biological Controls for Preventing Food Deterioration, 2014
- Essential Oils as Potential Alternative Biocontrol Products Against Plant Pathogens and Weeds: A Review,”. Foods, 2020. [PubMed]
- Antibacterial and Antifungal Properties of Essential Oils,”. Current Medicinal Chemistry, 2003. [PubMed]
- The Chemical Profiling of Essential Oils From Different Tissues of Cinnamomum camphora L. and Their Antimicrobial Activities,”. Molecules (Basel, Switzerland), 2021. [PubMed]
- Efficient Separation of Cinnamomum camphora Leaf Essential Oil and In Vitro Evaluation of Its Antifungal Activity,”. Arabian Journal of Chemistry, 2022
- Comparative Antifungal Activities and Biochemical Effects of Monoterpenes on Plant Pathogenic Fungi,”. Pesticide Biochemistry and Physiology, 2012
- Screening the Antifungal Activity of Essential Oils Against Decay Fungi From Palmyrah Leaf Handicrafts,”. Biological Research, 2014. [PubMed]
- Bioactivities and Compositional Analyses of Cinnamomum Essential Oils From Nepal: C. camphora, C. tamala, and C. glaucescens ,”. Natural Product Communications, 2013. [PubMed]
- The Effect of Some Essential Oils on Aspergillus niger and Alternaria alternata Infestation in Archaeological Oil Paintings,”. Mediterranean Archaeology and Archaeometry, 2018
- Antifungal Activity of Some Himalayan Medicinal Plants Using Direct Bioautographie,”. Journal of Molecular Cell Biology, 2006
- Volatile Metabolites From Salvia fruticosa as Antifungal Agents in Soilborne Pathogens,”. Journal of Agricultural and Food Chemistry, 2003. [PubMed]
- Osmitopsis asteriscoides (Asteraceae)‐the Antimicrobial Activity and Essential Oil Composition of a Cape‐Dutch Remedy,”. Journal of Ethnopharmacology, 2003. [PubMed]
- Chemical Characterization and Antifungal Activity of Cinnamomum camphora Essential Oil,”. Industrial Crops and Products, 2013
- Cinnamon and Citronella Essential Oils in the In Vitro Control of the Fungi Aspergillus Sp. And Sclerotinia sclerotiorum ,”. African Journal of Agricultural Research, 2018
- Essential Oils and Antifungal Activity,”. Pharmaceuticals, 2017. [PubMed]
- Antifungal Effect of Seven Essential Oils on Bamboo,”. Advanced Composites and Hybrid Materials, 2021
- Use of a Free Radical Method to Evaluate Antioxidant Activity,”. LWT Food Science and Technology, 1995
- Chemical Composition, Antioxidant and Antimicrobial Activities of Essential Oils From Leaves, Aerial Stems, Basal Stems, and Rhizomes of Etlingera fimbriobracteata (K.Schum.) R.M.Sm,”. Industrial Crops and Products, 2016
- The Ferric Reducing Ability of Plasma (FRAP) as a Measure of “Antioxidant Power”: The FRAP Assay,”. Analytical Biochemistry, 1996. [PubMed]
- A New and Rapid Colorimetric Determination of Acetylcholinesterase Activity,”. Biochemical Pharmacology, 1961. [PubMed]
- 78 P. Bernfeld , “Amylase α and β,” in Methods in Enzymology, ed. S. P. Colowick and N. O. Kaplan (Academic Press Inc., 1955), 149–150.
- Insulin Releasing and Alpha‐Glucosidase Inhibitory Activity of Ethyl Acetate Fraction of Acorus calamus In Vitro and In Vivo,”. Journal of Ethnopharmacology, 2010. [PubMed]
- Thymol Chemotype Origanum vulgare L. Essential Oil as a Potential Selective Bio‐Based Herbicide on Monocot Plant Species,”. Molecules (Basel, Switzerland), 2020. [PubMed]
- Mycoremediation Effect of Trichoderma harzianum Strain T22 Combined With Ozonation in Diesel‐Contaminated Sand”,. Chemosphere, 2020. [PubMed]
